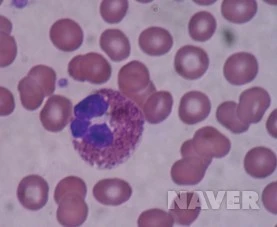
208_i9.jpg?type=h227_2&wm=Y

몸과 마음이 가벼워졌다
순례 008
팽나무 잎이 자라서
하늘을 가리었다 하늘이 보이지 않는다
비가 와도 팽나무 아래서 운동을 한다
거꾸리에 반듯하게 누워서 하늘을 본다
하늘은 보이지 않고 팽나무만 보인다
팽나무 가지와 팽나무 잎 안쪽만 보인다
이제는 몸이 많이 가벼워졌다 가벼워서
곁에 있는 기구들도 사용하기 시작한다
하늘 걷기를 시작으로 자전거 타기와
다리 뻗치기, 윗몸일으키기, 마라톤
둥그런 바퀴를 돌리며 상체 근육 풀기
하늘 밧줄 잡아당겨 오십견 치료하기
아, 몸이 가벼워지니 곁의 여울물소리도
징검다리를 통통통 가벼웁게 뛰어온다
월대천에 빗방울이 떨어져도 젖지 않는다
팽나무 잎이 자라서 연두 하늘을 펼쳤다
밤의 산책 혹은 밤의 명상
오늘은 달이 보이지 않는다
오랜만에 김광종 물길을 간다
안덕계곡에서 내려오는
은하수의 여울물 소리가 맑다
나는 누구를 만나려고 왔을까
자귀나무 잎은 꼬옥 끌어안고
곯아떨어졌고 멀구슬나무꽃은
자정이 넘도록 골똘히 생각 중
아, 나는 이 지상에서 이렇게
나를 깊숙이 만나려고 왔구나
다른 사람들은 결코 알 수 없는
오직 나만 알 수 있는 나를 만나려고
이렇게 아프고 슬프고 깊이 왔구나
돌아보면 저 밤의 여울물 소리처럼
아무도 모르게 참 많이도 울었구나
나도 이제는 곧 바다를 만나겠구나
바다에는 또 다른 나들이 있겠구나
몸도 비우고 마음도 비우고 관계까지
깨끗하게 정리하니 날개가 돋는구나
가만히 생각하니
가만히 생각하니
나는 내가 고맙다
가만히 생각하니
나의 몸이 고맙다
나는 아직도
심장 벽이 두껍다
나는 앞으로도
좌심실 벽이 두껍다
대동맥판막 앞에만
겨우 넓혀놓고 산다
넓히면서 신경도 차단이 되었다
동방결절 신호가 차단이 되었다
그래도 지금껏 잘 살아주었다
참으로 고마운 일이다 이제
나는 그 고마운 마음으로 산다
고마운 내 몸을 위하여
이제는 꽃보다 채소를 심는다
피와 골수와 우편배달부
피는 어떻게 만들어지는 것일까
피는 어떻게 배달을 하는 것일까
피는 무엇을 위하여 사는 것일까
피는 무엇을 업어서 배달하는가
피는 어째서 물보다 진한 것일까
피는 어째서 눈물로 다시 흐를까
피를 찾아서 깊숙이 순례를 한다
우리들이 음식을 먹으면 어떤 과정을 통하여 에너지로 바뀌는 것일까?
소화 과정 & 대사 과정
우리들이 음식을 먹으면
입에서 식도를 타고 내려간다
위에 도착하면
위에서 일부가 소화를 한다
그리고 십이지장을 거쳐
소장에 이르게 된다
대부분의 영양소는
바로 이 소장에서 소화가 된다
소장 내부의 융털에는
모세혈관과 암죽관이 있다
암죽관에서 흡수한 양분은
바로 심장 속으로 들어가고
모세혈관에서 흡수한 양분은
간을 거쳐서 심장으로 간다
(그만큼 중요하기 때문에 이중으로 했으리라)
그리고 대장에서는 소화작용은 없다
다만 수분만을 흡수할 뿐이다
세상에는 그렇게 큰 것보다
작은 것이 더욱 중요할 때가 많다
이제 피 속으로 들어간 영양소는
핏줄 속을 돌며
필요한 세포에게
골고루 나누어줄 것이다
넓게 생각하면
소화 과정도 대사 과정에
포함될 수 있겠으나
보통은 여기서부터
대사 과정이라 할 수 있을 것이다
대사 과정의 시작은
미토콘드리아가 될 것이다
미토콘드리아에서
양분과 산소가 만나서
에너지 발전소를 가동할 것이다
그리하여
세포 및 생체에서 사용할 수 있는 에너지인
ATP를 다량 생산하게 될 것이다
그러므로 우리들은
에너지 발전소이며
에너지 충전소인
미토콘드리아의 건강에
각별히 신경을 써야만 할 것이다
혈액 [ blood, 血液 ]
요약 혈관 속을 흐르고 있는 액상의 조직.

혈액의 성분
혈액은 혈구와 혈장으로 구성되어 있다. 혈구는 적혈구, 백혈구 및 혈소판으로 이루어져 있고, 혈장은 주로 수분으로 이루어져 있으며 여기에 생명유지에 필수적인 혈액응고인자, 전해질 등이 포함된다. 혈액은 옅은 노란색인데 붉은색으로 보이는 이유는 혈액 속에 포함된 적혈구가 붉은색이기 때문이다. 성인의 혈액 속에 포함된 적혈구는 약 25조 개로 알려져 있다. 인간의 전체 혈액량은 약 4~6ℓ 정도이며, 체중의 약 8%를 차지하고 있다. 물을 마시거나 적은 양의 출혈이 있을 때도 혈관 속을 순환하는 혈액량은 자율적으로 조절되어 전체 혈액량은 항상 일정하게 유지된다. 대량의 물을 마셨을 때 수분은 곧 혈액에서 조직으로 나가거나 신장으로부터 배설된다.
혈액의 주된 역할은 각종 물질의 운반이며, 폐에서 섭취한 산소나 소화관에서 흡수한 영양소 등을 전신으로 보내고 세포에서 만들어진 탄산가스나 노폐물을 운반해서 폐·신장·피부 등을 통해 몸 밖으로 배설한다. 또 골격근이나 간과 같이 열생산이 왕성한 곳에서 다른 부분으로 열을 옮겨서 체열(體熱)의 분포를 균등하게 하는 역할을 한다. 림프와 함께 체내의 면역체계에도 관여하고 있다. 혈장에는 혈액에서 약 55%를 차지하고 있으며 각종 나트륨, 칼륨 등 각종 미네랄 영양소와 호르몬 등이 포함되어 있다. 그 외에도 혈액이 흐르면서 신체의 각 부분으로부터 유입된 물질을 함유하고 있다. 혈구는 혈액에서 약 45%를 차지하며 적혈구가 대부분이다. 적혈구는 산소를 운반하고, 백혈구는 외부로부터 침입한 바이러스와 싸운다. 혈소판은 출혈을 멈추게 한다. 혈액에는 다양한 성분이 포함되기 때문에 혈액을 통해서 신체의 상태를 파악할 수 있다.
혈액과 같은 삼투압의 식염수를 생리적 식염수라 한다. 만약 혈액보다 낮은 삼투압의 식염수에 혈액을 넣으면 혈구 속에 수분이 빨려 들어가 부풀어 마침내는 파괴되며 이를 용혈(溶血)이라 한다. 반대로 혈액보다 높은 삼투압의 식염수 안에서는 혈구 속의 수분이 밖으로 나와 혈구가 오그라든다. 혈액의 pH는 약 7.4로 약한 알칼리성이다. 생체 내에서는 끊임없이 물질대사가 진행되고 있으며 탄산가스나 인산 등이 대사산물로 생성되고 있음에도 불구하고 혈액의 완충작용에 의하여 pH는 항시 일정 치를 유지하고 있다.
적혈구와 백혈구, 혈소판은 골수에 있는 조형 줄기세포에서 만들어지는데 적혈구는 하루 약 2000억 개가 만들어지고 백혈구와 혈소판은 하루에 약 1000억 개의 혈소판이 만들어진다. 혈액이 흐르는 혈관은 심장에서 나오는 동맥과 심장으로 들어가는 정맥 그리고 신체의 각 부분으로 세세하게 연결된 모세혈관을 타고 흐른다.
혈액
혈액이 하는 일
1. 혈관과 혈액
혈액은 우리 몸의 어느 한 곳에 머물지 않고, 심장에서 시작하여 동맥, 모세혈관, 정맥을 거쳐 다시 심장까지 온몸을 돌고 돈다. 이렇게 혈액이 지나가는 길을 혈관이라고 하며, 우리 몸의 혈관을 모두 연결하면 12만 km나 된다. 이것은 고속도로를 타고 서울과 부산을 약 200번 정도 왕복하는 길이이다.
1) 혈관의 종류
① 동맥
혈액을 심장에서 몸의 각 부분으로 보내는 혈관이다. 심장의 강한 압력을 견딜 수 있도록 두껍고 탄력 있는 근육층이 발달했다. 동맥을 흐르는 혈액에는 산소와 영양분이 많이 포함되어 있다.
② 모세혈관
동맥의 혈액이 온몸 구석구석까지 닿을 수 있게 그물처럼 뻗어 있는 혈관이다. 하나의 세포층으로 이루어진 얇은 벽을 통해 산소와 이산화탄소, 영양분과 노폐물이 교환된다.
③ 정맥
이산화탄소와 노폐물을 얻은 혈액이 모세혈관을 빠져나와 심장으로 돌아오는 혈관이다. 심장에서 멀리 떨어져 있어 혈액의 흐르는 힘이 약하기 때문에, 혈액이 거꾸로 흐르지 않게 하는 정맥 판막을 가지고 있다.

우리 몸의 혈관도

2) 혈액의 역할

혈액의 구성 요소혈액을 원심 분리기로 분리하면 혈장과 혈액세포로 나뉘는 것을 확인할 수 있다.
우리 몸무게의 약 8% 정도를 차지하는 혈액은 55%의 혈장과 45%의 혈액세포(혈구)로 이루어져 있다. 혈장은 물과 영양분, 호르몬 등이 섞인 노란 액체이며, 혈액세포는 혈장 속을 떠다니는 적혈구나 백혈구 같은 세포들을 말한다.
① 물질 운반
혈액은 산소뿐 아니라 단백질, 비타민 등 생존에 꼭 필요한 물질들을 온몸에 전달하는 운반의 역할을 담당한다. 또한 세포 활동으로 생긴 이산화탄소를 받아서 허파를 통해 배출시키고, 노폐물을 간이나 콩팥으로 보내 분해하거나 오줌 등을 통해 몸 밖으로 내보낸다.
② 면역 기능
혈액에 세균이나 바이러스 같은 침입자가 들어오면 혈액세포인 백혈구가 이들을 막는다. 백혈구는 식세포 작용으로 세균을 삼켜서 분해하고, 한 번 침입한 세균에 대해서는 대항하는 항체를 생산하여 같은 병에 다시 걸리지 않도록 한다.
③ 체온 조절
우리 몸의 여러 기관은 일을 할 때 열을 발생시키는데, 혈액은 우리 몸의 열이 한쪽에 치우치지 않도록 몸속을 돌며 열을 골고루 분배한다. 또 환경에 따라 우리 몸의 체온을 조절하기도 하는데, 주위 온도가 높아지면 피부 가까이로 흘러 공기 중에 열을 발산하고 낮아지면 몸 안쪽에 모여 체온을 보존하는 것도 혈액의 역할이다.

기온에 따른 혈액 분포
2. 혈액 세포
1) 적혈구

혈액 속의 적혈구 1초에 200만 개씩 파괴되고 새로 만들어지며, 이 과정에서 이상이 생기면 빈혈 증상이 나타난다.
적혈구는 헤모글로빈이라는 붉은색 단백질을 이용해 산소를 운반하는 혈액세포이다. 양면이 오목한 원반 모양으로 좁은 모세혈관을 통과하기 쉬우면서도 면적이 넓어 최대한 많은 산소와 접촉할 수 있다.
우리 몸의 혈액에는 1㎣당 약 500만 개의 적혈구가 있다. 적혈구의 수명은 120일 정도이며, 세포의 재생을 담당하는 핵이 없어 손상을 입으면 회복이 불가능하다. 따라서 손상을 입거나 노화된 적혈구는 간이나 지라, 골수에서 파괴되며 그때 나온 성분은 새로운 적혈구를 만드는 데 재활용된다.
2) 혈소판
혈액세포의 하나인 혈소판은 상처가 났을 때 피를 멈추게 하는 역할을 한다. 혈관을 다쳐 혈소판이 공기와 접촉하면 효소의 작용으로 트롬빈이라는 단백질 분해 효소가 활성화된다. 트롬빈은 피브리노겐이란 단백질 성분을 실처럼 가느다란 피브린 섬유로 만들며, 이것이 혈액세포들과 그물처럼 엉겨 굳으면서 딱지가 만들어진다.
혈소판은 혈액 1㎣당 30~50만 개가 있으며, 부족할 경우 멍이 잘 들고 쉽게 코피가 난다. 유전병 중 하나인 혈우병은 트롬빈을 활성화시키는 효소를 만드는 유전자가 없어서, 상처가 나도 혈액이 굳지 않고 출혈이 계속되는 병이다.

혈소판의 작용액체 상태인 피브리노겐이 혈소판에 의해 고체 상태의 피브린 섬유로 변하면서 딱지가 생긴다.

3) 백혈구
백혈구는 우리 몸을 질병으로부터 보호하는 혈액세포로, 세균이나 바이러스 같은 이물질이 몸속에 들어오면 삼켜서 분해하거나 항체를 만들어 공격한다. 아메바처럼 모양이 일정하지 않고 몸을 자유자재로 늘였다 줄였다 할 수 있기 때문에, 이물질이 들어오면 세포와 세포 사이의 좁은 틈을 통해 이물질이 침입한 곳으로 바로 이동해 공격할 수 있다.
혈액 1㎣당 6~8천 개가 있으며 세포 안에 작은 알갱이들(과립)이 있느냐 없느냐에 따라 과립성 백혈구와 무과립성 백혈구로 나뉜다. 이들은 다시 여러 종으로 분리되며, 각각 우리 몸 안에서 서로 다른 역할을 한다.
종류 특성 기능
과립성 백혈구
백혈구 중 가장 많으며, 세포 안에 면역 효소가 든 알갱이들이 있다.
• 호중구 - 세균을 직접 잡아먹는 식세포 작용
• 호산구 - 기생충에 대한 방어
• 호염기구 - 이물질에 대한 알레르기 반응
무과립성 백혈구
림프구
둥근 모양의 세포로, 면역 반응에 직접 작용한다.
• B림프구 - 세균 활동을 막는 항체 생산
• T림프구 - 면역 활동을 지휘, 세균을 직접 공격
• 자연살해세포 - 감염된 세포와 암세포 분해
단핵구
백혈구 중 가장 크며, 둥글거나 말굽 모양의 핵이 있다.
• 큰 포식세포 - 식세포 작용, 림프구에 도움 요청
• 가지세포 - 세균 분석, 면역 활동 촉진

호산구직경 약 9~10㎛로 적혈구보다 조금 크며, 알레르기 반응에 관여한다.

큰 포식세포의 식세포 작용가장 큰 백혈구로, 몸의 한 부분을 길게 뻗어서 세균을 잡아먹는다.





사람의 소화
동물의 소화기관은 그 동물의 생활환경에 따라 다르다. 아메바와 같은 단세포동물은 소화기관의 분화가 없고, 체표면 전체에서 먹이를 섭취한다. 이들은 먹이가 체표면에 도달하면 세포막이 먹이를 싸고 안으로 함입하여 식포(食胞)라는 주머니를 형성한다. 이어 이 식포는 세포막에서 유리되고, 세포 내부에 있던 리소좀(lysosome)이라는 작은 주머니가 식포에 유착하면서 그 속에 들어 있는 각종 소화효소(가수분해 효소)를 식포 속으로 주입하여 섭취한 먹이를 소화한다.
이렇게 소화된 분해산물은 식포에서 세포 속으로 흡수된다. 이와 같은 소화는 세포 속에서 일어난다고 하여 흔히 세포내소화라고 말하나, 식포는 세포 외 환경을 둘러싸서 세포 내에 끌어들인 것이고, 소화는 이 식포 속의 세포 외 환경에서 일어나는 것이므로 엄밀한 의미에서는 세포내소화가 아니다. 사실 모든 동물에서 세포내소화라는 현상은 존재하지 않는다. 회충이나 촌충처럼 고등동물의 소화관 속에 기생하는 동물은 숙주(宿主) 동물이 소화해 놓은 영양분을 바로 흡수하여 생활하기 때문에 자체의 소화기관은 극도로 퇴화되어 있다.
사람에서의 소화과정은 소화기관을 중심으로 설명하면 다음과 같다.

입에서의 소화
음식물이 입 속에 들어오면 우리는 이것을 씹어 잘게 부수게 되는데, 이것은 고형(固形) 음식물을 분쇄하여 소화효소의 작용 표면적을 넓힌다는 것과 삼키기 쉬운 형태로 만든다는 두 가지 의미가 있다. 고형물질의 질량에 대한 표면적의 비는 고형입자의 크기가 작아질수록 커지기 때문에 잘 씹을수록 소화효소의 작용표면적도 넓어져서 소화가 잘 된다. 입에서는 귀밑샘[耳下腺] ·혀밑샘[舌下腺] 그리고 턱밑샘[顎下腺]의 세 곳에서 분비되는 침 속의 소화효소에 의하여 약간의 소화가 이루어진다.
위의 세 샘을 침샘[唾腺]이라고 하는데, 이 침샘에서의 침의 분비는 거의 전적으로 신경의 지배를 받고 있다. 따라서 실제로 음식물을 먹지 않더라도, 상상하거나 냄새를 맡거나 또는 음식을 보기만 해도 대뇌피질에서 자극이 연수(延髓)에 도달되어 침샘자극신경을 흥분시켜 침이 분비된다. 침 속에는 아밀레이스라는 소화효소가 들어 있는데, 이것은 녹말을 말토오스로 분해한다. 말토오스는 단맛이 있어서 우리가 음식물을 입 속에서 오래 씹고 있으면 단맛을 느끼게 된다. 그러나 음식물이 입 속에 머무는 시간은 보통 길지 않으므로 입 속에서의 소화는 매우 짧다.
위에서의 소화
입에서 음식물은 죽처럼 부드럽게 된 다음 식도를 통하여 위로 들어가는데, 이 식도에 이르는 과정은 고도로 조화된 반사작용의 결과이다. 즉, 음식물이 혀의 작용으로 목에 도달하면 입천장이 위로 밀려 올라가서 비강(鼻腔)과 인두(咽頭) 사이를 차단하여 음식물이 비강으로 들어가는 일이 없도록 하고, 또 후두(喉頭)와 인두 사이도 차단되어 음식물이 기관(氣管) 속으로, 그리고 폐로 들어가지 못하게 한다. 이들 작용은 모두 반사작용이어서 우리가 의식하지 않아도 저절로 이루어진다. 그러나 간혹 이 반사작용이 완성되기 전에 음식물의 일부가 비강이나 후두로 들어가면 제2의 반사, 즉 심한 재채기 등의 근육운동이 일어나서 들어갔던 음식물을 구강 속으로 되돌려 보내는 반사작용이 일어난다.
이와 같은 반사작용의 결과 음식물이 인두를 거쳐 식도로 들어가면, 식도를 구성하는 근육의 반사적인 수축운동으로 음식물은 위(胃)로 내려간다. 위에서는 위벽으로부터 위액이 분비되는데, 위액 속에는 염산(HCl)과 펩시노겐이라는 소화효소가 들어 있다. 이 염산 때문에 위액은 극도로 산성이어서 pH가 1∼2 정도로 낮다. 그러나 펩시노겐은 이 염산의 작용을 받아 펩신이라는 물질로 전환되고, 이 펩신이 단백질을 가수분해한다. 그리고 펩신은 pH 1∼2 정도의 강한 산성용액 속에서 그 작용이 가장 활발하기 때문에 위액의 염산은 펩신에 의한 단백질의 가수분해에 매우 큰 의의가 있다. 또, 이 염산은 음식물에 묻어서 들어온 많은 박테리아를 죽이는 살균작용도 하고 있다. 우리가 신트림을 하였을 때 느끼는 신맛은 이 염산으로 인하여 위액이 산성을 띠고 있기 때문이다.
위액 속의 펩시노겐은 이 염산으로 활성화되어 단백질을 분해하는데, 이 펩신은 특정 아미노산이 있는 부위만 선택적으로 가수분해하기 때문에 단백질은 여러 가지 길이의 토막으로 잘릴 뿐이고 그 구성 아미노산으로 정말 분해되지는 않는다. 또, 입에서 음식물과 같이 내려온 침 속의 아밀라아제는 위 속이 pH 2인 산성이므로 그 작용을 전혀 나타낼 수 없어서 녹말의 가수분해도 위에서는 거의 일어나지 않는다. 따라서, 위에서의 소화는 단백질의 부분적 가수분해에 그칠 뿐이다. 위액에는 뮤신이라는 성분이 들어 있어서 이것이 위벽을 염산과 펩신의 작용으로부터 보호하고 있다.
소장에서의 소화
위에서 어느 정도 지체한 음식물은 서서히 소장으로 옮겨간다. 사람의 소장은 길이 약 7m인 긴 관으로, 위와의 접촉부위로부터 약 30 cm를 십이지장이라 하고, 그다음 약 2m의 부분을 공장(空腸), 나머지 부분을 회장(回腸)이라고 한다. 이 소장에서는 장액(腸液)이 분비되는데, 장액 속에는 여러 가지 소화효소가 풍부히 들어 있어서 음식물의 소화는 거의 전적으로 소장에서 이루어진다. 그리고 소화 산물의 흡수도 대부분 소장에서 이루어진다. 소장은 주기적으로 연동운동(蠕動運動)을 한다.
이 운동은 소장이 한쪽에서부터 서서히 수축하면서 음식물을 대장 쪽으로 밀어내고, 또 부분적으로 부풀었다가 수축하였다가 하면서 내용물을 뒤섞는 반사운동이다. 이렇게 함으로써 음식물은 소화효소에 의하여 충분히 분해되면서 또 흡수되고, 소화되지 않은 찌꺼기가 대장으로 밀려나간다. 소장에서 분비되는 소화효소는 그 종류가 대단히 많다. 또, 이자에서 분비되는 이자액이 십이지장으로 들어와서 소화를 돕고, 간에서 만들어진 쓸개즙[膽汁]이 쓸개주머니[膽囊]에 저장되어 있다가 역시 십이지장 속으로 분비된다.
이자액 속에는 단백질을 분해하는 트립신, 녹말을 분해하는 아밀라아제, 지방을 분해하는 리파아제 등이 들어 있다. 쓸개즙 속에는 소화효소는 없으나 지방의 분해를 용이하게 하는 각종 유기산염이 들어 있어서 물에 안 녹는 지방을 에멀션으로 만들어 잘 분해되게 한다. 또, 소장의 벽에서 분비되는 장액 속에는 펩티다아제 등의 단백질 분해효소, 말타아제 ·수크라아제 등 탄수화물 분해효소, 리파아제 등 지방 분해효소들이 들어 있어서 소화를 완결시킨다. 이러한 소화효소들의 작용으로 단백질은 아미노산으로, 녹말과 같은 고분자 탄수화물은 포도당으로, 그리고 지방은 지방산(脂肪酸)과 글리세롤로 각각 가수분해된다.
소장의 내벽은 무수히 많은 주름이 잡혀 있어서 그 표면적이 대단히 넓다. 그리고 이 주름 속에 림프관과 모세혈관이 그물처럼 분포되어 있어서 소화산물을 흡수한다. 아미노산과 포도당은 이 모세혈관으로 흡수되어 간(肝)에 이르고, 지방산과 글리세롤은 림프관 속으로 흡수된다. 위액과 장액의 분비는 신경의 지배를 크게 받고 있으며, 또 가스트린과 세크레틴이라는 호르몬에 의하여 조절되고 있다.
대장에서의 작용
소장에서 소화가 다 되고 난 뒤의 찌꺼기는 대장으로 내려간다. 대장에서는 소화작용이 없고, 주로 물의 흡수가 일어난다. 즉, 소장에서 내려온 내용물은 수분함량이 많은데, 이 물이 대장에서 흡수되어 찌꺼기는 점점 고형화(固形化)되면서 대변으로 굳어지는 것이다. 대장 속에는 무수히 많은 대장균이 서식하고 있어서 대장으로 내려온 소화되지 않은 것을 일부 분해하면서 살고 있다. 대장에서 굳어진 내용물은 직장(直腸)으로 내려가서 뒤에 대변으로 배설된다.
[네이버 지식백과] 사람의 소화 (두산백과 두피디아, 두산백과)
영양소의 소화흡수
수분을 제외한 식품성분의 고형물질 중에서 대부분이 탄수화물 ·지방 ·단백질의 3대 영양소로서, 이들은 대부분 분자의 크기가 커서 소화관을 통하여 바로 흡수되지 못하고 단당류 ·아미노산 ·지방산 ·글리세롤 같은 간단한 물질로 분해된 다음 흡수된다. 이와 같이 음식물 속에 들어 있는 영양소가 위장 ·소화기관을 거치는 동안 체내로 흡수될 수 있는 상태로 되는 과정을 소화라 한다.
소화작용은 침 ·위액 ·췌액 ·소장액 등의 소화액에 들어 있는 여러 종류의 소화효소에 의하여 이루어지며, 소화된 물질은 대부분 소장에서 흡수된 후 혈액으로 운반되어 혈류를 따라 세포에 도착하여 대사과정을 거친다. 소화흡수되지 않은 식품의 성분들은 대변을 형성하여 대장을 거쳐 배설된다.
식품의 소화흡수율은 식품 속의 성분, 다른 식품과의 배합비율, 가공조리 등에 따른 영향을 받으며, 식품을 먹는 사람의 건강상태 ·정신상태 ·노동량 ·식품섭취량 등에 의해서도 달라진다. 영양소별로는 일반적으로 당질이 가장 흡수율이 좋고, 다음은 동물성 단백질 ·지방 ·식물성 단백질의 순서이다.

식품성분 중 섬유질은 사람의 장 속에서 소화되지 않으며, 장의 운동을 자극하여 장 내용물의 통과속도를 높임으로써 소화흡수율을 떨어뜨린다. 섬유질은 곡류 ·채소 ·과일류 등 식물성 식품에 많이 함유되어 있으며, 곡류에는 껍질 부분에 많기 때문에 곡류 도정도에 따른 소화흡수율의 차이를 나타낸다. 또 가공조리 정도에 따라, 특히 가열조리에 의하여 녹말의 호화, 단백질의 변성, 지방의 용출, 식품조직의 연화 등 성분변화가 일어나 소화성이 증가된다. 한국 평균 혼합식의 단백질 소화흡수율은 약 80 %라고 연구조사되어 있는데, 이러한 차이는 섭취하는 음식내용이 다른 까닭이다.
[네이버 지식백과] 영양소의 소화흡수 (두산백과 두피디아, 두산백과)
물질대사 [ Metabolism]
생명체가 살아가는데 필수 불가결한 물질의 화학적 변화
어원 및 정의
대사는 그리스어로 변화를 뜻하는 metabole에서 유래된 말로 세포나 생명체가 살아가는데 필수 불가결한 물질들의 화학적 변화를 의미한다. 대사는 다음의 3가지 목적을 가지고 행해진다. 1) 생체나 세포의 각종 생명 과정을 진행하기 위한 에너지를 얻기 위해 에너지원이 되는 물질로부터 에너지 원 물질을 변환시키는 것, 2) 생체나 세포의 구조 (building block)를 만들거나 유지하기 위한 단백질, 지질, 탄수화물 등을 얻거나 만드는 것, 3) 생명 현상에서 쓰고 남거나 버리게 되는 물질을 처리하는 것 등이다. 이러한 과정은 효소의 촉매 작용 때문에 대부분 일어나며 이러한 과정이 성공적으로 이루어짐에 따라 성장, 생식이 가능해지고 세포 및 생명체의 구조를 만들고 유지하게 되며 환경의 변화에 대처할 수 있게 된다. 대사는 생체 전체에 관해서 얘기할 때에는 음식의 섭취, 소화, 배설, 조직 간 이동 등 거시적인 것을 의미하기도 하며 세포에서 일어나는 미시적인 대사는 중간 대사 (intermediary metabolism)이라고 부른다 (1, 2).
대사의 기본 물질
아미노산
아미노산은 단백질을 이루는 기본 단위이며 아미노산이 아마이드 결합을 통해 길게 연결된 것이 펩티드 (peptide)이다. 펩티드가 50개 이상의 아미노산으로 구성되어 입체 구조를 가지면 단백질이라고 부른다. 단백질은 생체 및 세포의 구조의 중요 성분이며 또한 많은 단백질은 효소로 작용한다. 글루타민 등 아미노산은 또한 시트르산의 여러 구성 성분으로 변환되기도 하여 당과 상호 변환될 수 있다.
지질
지질은 세포의 원형질막의 중요 성분이며 경우에 따라서는 에너지 원으로 직접 쓰이기도 한다. 지질은 주로 소수성 (hydrophobic)하거나 양친성 (amphiphilic)이며 벤젠, 클로로포름 등 유기 용매에 잘 녹는다. 지질은 생체 내의 여러 물질 중 가장 다양한 물질로 구성되어 있으며 지방산 (fatty acid), 글리세롤 (glycerol), 콜레스테롤, 인지질 (phospholipid), 스핑고지질 (sphingolipid) 등과 이들의 다양한 결합체들이 모두 지질에 속한다.
탄수화물
탄수화물은 알데히드 또는 케톤에 여러 개의 수산기가 결합한 형태이며 선형 구조 (linear structure) 또는 고리 구조 (ring structure)를 이루고 있다. 탄수화물은 생체 내 또는 세포 안에서 가장 양적으로 많은 물질이며 가장 중요한 에너지 원으로 쓰이고 구조 성분 (building block)으로도 중요하다. 한 개의 분자일 경우 단당류, 2개의 분자가 연결되었을 때 이당류, 그 이상이면 다당류로 불리며 결합 방법에 따라 무수한 종류의 탄수화물이 만들어진다. 탄수화물을 지질 및 단백질과 결합하여 당지질 (glycolipid) 및 당단백질 (glycoprotein)를 형성하며 이들은 생체 및 세포의 중요 구성 성분이다.
뉴클레오티드 (nucleotide)
뉴클레오티드에는 DNA와 RNA의 2종류가 있으며 전자는 오탄당인 데옥시리보스 (deoxyribose)에 염기 (base) 및 인산기가 붙은 것이며 후자는 데옥시리보스 대신에 리보스 (ribose)가 들어간 것이 차이이다. 이것들이 길게 결합하여 폴리뉴클레오티드를 형성하고 DNA의 경우 수소결합 때문에 두 가닥이 연결되어 이중 나선 (double helix)를 만든다. DNA는 유전 정보를 축적하고 있는 물질이며 RNA는 DNA의 정보로부터 단백질을 합성하는 중간 전달 물질이 된다. 뉴클레오티드는 에너지 반응에 있어 조효소 (coenzyme)으로도 작용한다.
분류
대사는 크게 이화 작용 (catabolism)과 동화 작용 (anabolism)으로 나눌 수 있다. 전자는 유기 물질을 더 작은 물질로 분해하여 에너지를 얻는 과정이고, 후자는 에너지를 사용하여 어떤 물질을 더 단위가 큰 물질로 만들어 세포나 생체의 구성 성분을 만드는 과정을 뜻한다. 대사 과정을 보면 하나의 반응으로 시작하여 일련의 다른 반응과 계속 연결되어 하나의 연속적인 계통 반응을 이루고 있다. 이러한 과정은 연속적인 효소의 촉매 반응을 통해 이루어지며 자발적으로 또는 단독으로는 일어나기 힘든 화학적 반응이 효소의 작용에 의해 일어나게 된다. 이러한 효소의 연속 작용에 의해 생명체의 대사가 결정된다. 즉 어떠한 유기 물질이 있는 경우 어떤 효소에 의해 어떤 물질로 변환되는가에 따라 세포 또는 생명체 간에 유익한 물질 또는 화학반응이 될 수 있는 반면 다른 생명체 또는 세포 사이에서는 같은 유기 물질로부터 다른 효소 작용에 의해 해로운 물질이 생성되기도 한다. 이렇게 세포 및 생명체 간의 차이에 의해 대사 작용이 다르지만, 대사의 기본이 되는 물질에 대해서는 생명체 간에 놀라울 정도로 공통점이 있다. 예를 들면 시트르산 회로의 구성 물질인 여러 카르복시 산 (carboxylic acid)들은 박테리아로부터 포유류까지 같은 물질을 사용하고 있다. 이는 여러 생명체의 공동 조상이라고 생각되는 원시 생명체에서의 화학반응이 어떠했을까에 대한 정보를 제공하는 동시에 진화 과정에서 그 공통적 물질 또는 공통적 대사 과정의 효율성/안정성이 타 반응보다 생명 유지에 매우 효과적이고 우월할 것이라는 것을 의미한다.
이화 작용 (Catabolism)
이화 작용은 세포 내에서 큰 분자를 작은 분자로 쪼개지고 그때 발생하는 에너지를 세포가 이용하는 과정이다. 이러한 과정은 화학적 과정으로 열역학 제2 법칙을 따르며 발생하는 자유 에너지의 차를 세포가 이용하게 되는 것이다. 이러한 화학적 과정에서 기질이 활성화되어야 하고 활성화 에너지 (activation energy)가 필요하며 이것이 화학적 반응의 에너지 장벽으로 작용한다. 효소는 이 에너지 장벽을 낮추어 화학적 반응이 일어나기 쉽게 만든다. 이화 작용은 본질적으로 산소에 의한 물질 연소 반응 (combustion)에 의한 열 발생 (heat production)과 같으나 연소 반응에 의한 열 발생의 경우는 반응이 너무 급격하고 조절을 할 수없어 세포가 그 발생하는 에너지를 쓸 수 없는 반면에 이화 작용에서는 그 연소 반응이 무질서도가 감소하는 다른 반응과 연결 (coupling)이 되어 다른 형태로 에너지가 보존되어 세포가 이를 쓸 수 있게 되는 점에서 차이가 있다. 이화 작용은 다음과 같이 이루어진다.
소화 (digestion)
탄수화물, 지질, 단백질은 섭취된 후 체내에서 그러나 세포 밖에서 일단 세포가 흡수할 수 있는 형태로 분해된다. 다당류는 소화 효소에 의해 장에서 단당류로 분해되고, 지질은 지방 분해 효소에 의해 지방산과 모노아실 글리세롤 (monoacyl glycerol)로 분해되고, 단백질은 프로테아제에 의해 아미노산으로 분해되어 장의 상피 세포로 흡수된다. 이러한 영양소의 소화 및 분해에는 숙주로부터 분비된 소화 효소가 가장 중요하나 장내 미생물에서 유래된 효소 역시 중요한 역할을 한다. 따라서 장내 미생물에 이상이 생긴 경우에는 영양소의 흡수에 문제가 생길 수 있다.
산화적 인산화 (oxidative phosphorylation)
세포 및 생체 내에서 주된 에너지원이 되는 유기 물질은 탄수화물이다. 이것이 해당과정 (glycolysis)을 통하여 피루브산 (pyruvic acid)이 되며 이 과정에서 소량의 에너지가 발생한다. 피루브산은 미토콘드리아 내부로 들어가서 아세틸 CoA (acetyl-CoA)로 변환된 후 시트르산 회로 (citric acid cycle)를 통하여 세포 및 생체에서 사용할 수 있는 에너지인 ATP를 다량 생산함으로써 해당과정에 비해 훨씬 많은 에너지를 생산한다. 이러한 일련의 과정에서 에너지 전달체 (energy carrier)로 작용하는 것이 NADH이다. 해당과정과 시트르산 회로에서 생산된 NADH는 산화적 인산화 (oxidative phosphorylation) 과정을 거쳐 산소를 전자 수용체로 하여 대량의 ATP를 생산하게 된다. 지질의 경우는 지방산과 글리세롤로 분해되고 지방산은 베타 산화 (β-oxidation) 과정을 거쳐 아세틸 CoA로 변환되어 시트르산 회로로 진입하고, 글리세롤은 해당과정으로 들어와서 에너지를 생산하게 된다. 아미노산 중 글루타민 등 일부의 아미노산은 시트르산으로 진입하게 되고 일부는 당신생성 (gluconeogenesis) 과정을 거쳐 포도당으로 변환되기도 하며, 여러 아미노산은 요소 회로 (urea cycle)를 통해 분해된다 (2).
동화작용 (anabolism)
동화작용은 이화 작용과 반대로 작은 물질로부터 에너지를 사용하여 큰 물질을 만들어 가는 과정이다. 만들어진 큰 물질은 세포 또는 생체를 구성하는 구성 성분이 되는 경우가 많다.
광합성
동화작용의 가장 대표적인 예는 광합성 (photosynthesis)이다. 이 과정을 통하여 식물이 빛, 물, 이산화탄소로부터 탄수화물을 합성해 내고 그 과정에서 산소가 발생하여 그 산소를 호기성 생물이 이용하게 된다. 광합성은 빛이 있어야 하는 명반응 (light-dependent reaction)과 빛이 필요하지 않은 암반응 (light-independent reaction)으로 나뉜다. 전자에서는 빛 에너지로부터 에너지 전달체를 합성하게 되며 후자에서는 이를 이용하여 대기 중의 이산화탄소를 이용하여 탄소 고정 (carbon fixation)의 과정을 거쳐 탄수화물 (carbohydrate)을 합성하게 된다. 후자를 총체적으로 칼빈 회로 (Calvin cycle)이라고 부르기도 한다.
유기물질의 동화작용
유기 물질 중 탄수화물의 동화작용에서 대표적인 것은 포도당신생성 (gluconeogenesis)이다. 이를 통해 피루브산, 글리세롤 또는 다른 아미노산으로부터 포도당이 합성될 수 있다. 이 포도당신생성 과정은 단순히 해당과정의 역방향의 회로는 아니다. 몇 개의 효소는 해당과정과 포도당신생성 사이에 차이점이 있으며 이러한 차이로 인해 세포나 생체의 대사 환경에 따라 양자를 더 정밀하게 조절할 수 있다. 이렇게 생성된 포도당은 더욱 복잡한 다당류로 합성될 수 있어서 식물에서는 녹말, 동물에서는 글리코겐으로 변환된다. 지질의 경우는 아세틸 CoA로부터 ATP를 이용하여 지방산이 합성될 수 있고 다양한 길이의 포화 및 불포화 지방산이 합성된다. 지방산의 합성 과정에 오탄당 인산 경로 (pentose phosphate pathway)를 통해 생성된 NADPH가 사용된다. 지방산으로부터 글리세롤을 지주 (backbone)로 하여 체내의 에너지 저장에 널리 쓰이는 중성 지방 (triglyceride)이 합성될 수 있다. 또한, 각종 인지질, 당지질 등이 합성되어 세포 및 생체의 중요 구성 성분 (structural component)으로 될 수 있다. 콜레스테롤은 아세틸 CoA로부터 메발론산 (mevalonic acid)을 거쳐 생합성되며 이 과정 중의 HMG-CoA 환원효소 (HMG-CoA reductase)가 반응결정 단계 (rate-limiting step)에 작용하는 효소이다. 이 HMG-CoA 환원효소는 최근 널리 쓰이는 고지질혈증약인 스타틴 (statin) 계열 약물의 표적 효소 (target enzyme)이다. 단백질은 아미노산으로부터 뉴클레오티드 (nucleotide) 결합을 통해 합성되어 세포 및 신체의 구성 성분, 효소 등으로 작용한다. 일부 아미노산은 세포 또는 생체 내에서 합성되지만, 일부는 생체 내에서 합성되지 않기 때문에 꼭 섭취하여야 하며, 이것을 필수 아미노산 (essential amino acid)이라고 부른다. 여러 아미노산의 합성 및 대사는 시트르산 회로와 밀접하게 연결되어 있으며, 히스티딘 (histidine) 등은 오탄당 인산 (pentose phosphate) 경로의 산물인 5-인산 리보스 (ribose-5-phosphate)로부터 직접 합성되고, 글루타민 산 (glutamate) 등 일부 아미노산은 오탄당 인산 경로를 통해 합성된 NADPH를 이용하여 합성된다. 핵산의 합성에도 오탄당 인산 경로가 중요하여 그 과정에서 만들어진 5-인산 리보스로부터 5-포스포리보실 1-피로인산 (5-phosphoribosyl 1-pyrophosphate, PRPP)가 합성되고 이를 기본 물질로 하여 각종의 퓨린 (purine) 핵산이 합성된다. 이와 같은 핵산 신생성 (de novo synthesis) 이외에도 핵산의 이화 과정에서 발생하는 히포크산틴 (hypoxanthine) 및 구아닌 (guanine)을 다시 핵산 생합성에 사용하는 재활용 경로 (salvage pathway)도 중요한 핵산의 합성 경로이며 이 과정은 Hypoxanthine-guanine phosphoribosyltransferase (HGPRT) 효소를 통해 이루어진다.
위의 3대 대사 물질 이외에 미량 원소, 금속, 비타민, 조효소들도 대사 과정에 중요한 역할을 한다.
[네이버 지식백과] 물질대사 [Metabolism] (분자·세포생물학백과)

원혜영 “연명 치료·유산문제 미리 매듭지어야 ‘웰다잉’ 가능하죠” [세상을 보는 창]
김기동 2024. 5. 1. 06:05
정계 은퇴 선언 뒤 ‘인생 2막’ 연
원혜영 웰다잉문화운동 공동대표
초고령화 시대… 죽음 보는 시선 달라져
‘행복한 죽음 스스로 정하는’ 준비 필요
무의미한 연명치료에 연 2조 원 쓰는 韓
고통만 가중… 적극적 선택지 주어져야
死 언급 꺼리는 문화 탓 0.5%만 ‘유언장’
삶 정리하는 것… 재산 떠나 반드시 남겨야
세계이슈인 존엄사, 심도 깊게 논의할 때
‘웰 다잉(well dying)’. 품위 있고 존엄하게 생을 마감하는 것이다. 표준 영어가 아닌 콩글리시이지만 죽음조차도 행복하게 승화시키는 긍정적 측면을 부각한 단어다. 죽음도 삶의 중요한 일부분이라는 반어적 의미가 담겼다. 5선 국회의원과 부천시장을 역임한 원혜영(74) 웰다잉문화운동 공동대표는 “초고령사회를 맞아 행복한 죽음은 스스로 결정해야 한다. ‘자기 결정권’을 통한 아름다운 죽음은 21세기 어젠다”라고 강조했다. 그는 “후원요청 과정에서 죽음을 언급하다 보니 처음에는 거부감을 갖는 사람도 있었지만 시대가 달라졌다. 죽음은 결코 회피한다고 해법이 나오는 게 아니다”라고도 했다. 2019년 정계은퇴를 선언한 뒤 웰다잉 운동 전도사로 변신해 인생 2막을 살고 있는 원 대표를 지난 25일 서울 서대문구 사무실에서 만났다.

원혜영 웰다잉문화운동 공동대표가 지난 4월 25일 세계일보와 인터뷰에서 “삶을 아름답게 마무리하는 건 21세기 어젠다”라며 “1000만 고령자 사회에서 무의미한 연명치료와 상속 분쟁을 줄이려면 죽음에 대한 ‘자기 결정권’이 무엇보다 중요하다”라고 강조하고 있다. 최상수 기자
―웰다잉 운동을 정확히 설명해 달라.
“사전연명의료의향서나 유언장을 미리 써 무의미한 연명치료를 거부하는 한편 재산상속에 따른 분쟁도 줄이고 일부를 사회에 기부하자는 것이다. 연명치료는 병원이, 장례는 상업주의가 만연한 장의사가 맡는다. 유산은 분쟁으로 이어지면서 결국 법원이 개입하게 된다. 연명의료를 중단하면 의료비가 줄고 작은 장례식은 가계에도 보탬이 된다.”
―어떤 일이 계기가 됐나.
“2008년 세브란스병원 ‘김할머니 사건’으로 존엄사 논쟁에 불이 붙었다. 할머니 가족이 연명치료를 거부했고 대법원도 헌법에 따른 행복추구권이 보장돼야 한다고 했다. 하지만 병원 측은 법적 미비에 따른 처벌을 이유로 이행하지 않았다. 이후에도 유사한 일이 발생해 논란은 반복됐다. 결국 각계에서 호스피스 완화 운동이 일어났고, 동료 의원들과 함께 연명의료결정법(2016년)을 제정한 것이다. 지금까지 사전연명의료의향서를 쓴 사람이 200만 명이 넘었다.”
―법 제정 이후 달라진 게 있나.
“죽음에 대한 사회적 인식이 바뀐 게 큰 변화다. 웰다잉 문화의 핵심은 초고령사회를 맞아 1000만 명이 넘는 고령층에 주목해야 한다. 자본주의의 두 축인 생명과 재산문제는 언제, 어떤 형태로든 명확히 매듭지어주는 게 맞다. 무기력하게 체념하고 살다가 의식이 없는 상황에 처하기 전에 스스로 삶에 대한 결정을 내리는 게 어찌 보면 당연한 거 아닌가. 아무런 준비도 없이 과도한 장례비에 바가지를 쓰거나, 갑자기 쓰러졌을 때 후견인 선정을 놓고도 분란이 일어난다. 재산분배는 더 큰 분쟁을 가져온다. 그런 것을 미연에 방지하자는 것이다.”
―현행 법의 문제는 없나.
“당시 법을 만드는 과정에서 생명을 중시하는 종교계 반대 등으로 많은 우여곡절을 겪었다. 이해와 설득을 거치면서 연명의료중단 범위나 시기가 제한된 것은 아쉽다. 8년간 시행하는 과정에서 큰 우려는 사라졌지만 현실적 제약은 여전했다. 단적인 예가 인공호흡기와 음식물 섭취다. 호흡이나 물, 영양섭취는 자연스러운 생리현상이다. 가장 먼저 영양섭취 장애가 오고 호흡은 마지막 단계다. 현행법으로는 인공호흡기를 떼는 건 허용되지만 음식물을 끊어서는 안 된다. 모순이다.”

―유언장 남기기 운동도 하는 건가.
“그렇다. 나 역시도 매년 유언장을 작성하면서 삶을 되돌아보곤 한다. 평생 피땀 흘려 모은 재산은 많고 적음을 떠나 스스로 정리하는 게 옳다. 웰다잉문화운동본부 홈페이지에 유언 무료 상담센터를 연 이유다. 유언장은 반드시 필요하다. 선진국은 이미 유언장 문화가 널리 퍼져 있지만 우리나라는 0.5%에 불과하다. 물려줄 재산이 많고 적은 게 이유라기보다는 아직도 살아 있을 때 죽음을 언급하기를 꺼리는 문화와 사회적 인식 탓이 크다.”
―헌법재판소가 형제자매에게 유산상속 강제하는 유류분에 대한 ‘위헌·헌법불합치’ 결정을 내렸다.
“웰다잉에서 중요한 문제다. 사망자 의사와 상관없이 자녀에게 법정상속분의 2분의 1을 줘야 한다. 80∼90세가 넘어 세상을 떠나는 추세에서 자식도 이미 은퇴한 노년층이다. 시대가 바뀌었는데 47년 만에 ‘위헌’ 결정이 내려진 건 늦은 감이 있다. 자식이라고 의무적으로 주는 건 맞지 않다. 사회적 생산성 측면에서 보면 오히려 자식보다는 손자·손녀에게 주는 게 나을 수도 있다.”
―국회가 후속입법을 서둘러야 하나.
“그렇다. 본인의 의사결정이 배제된 순간부터 유산분배를 놓고 다툼과 분쟁이 급증한다. 상속재판 건수가 이혼재판을 앞지른 지 오래다. 대부분이 1억 원 이하 소송물 가액이라는 점에서 죽음이 가족 간의 불화로 이어진다는 얘기다. 연간 상속분쟁이 5만 건이 훌쩍 넘는 상황에서 유언장(사전연명의료의향서 포함)은 절대적인 힘을 발휘한다. 스스로 생명과 재산 두 가지를 결정하는 것만이 가족들의 고통을 최소화하고 아름다운 이별을 맞을 수 있다.”
―웰다잉으로 사회적 비용도 줄이나.
“죽음을 돈으로 따지는 게 조심스럽지만 현실을 고려하지 않을 수 없다. 환자가 평생 쓰는 의료비 가운데 절반이 생의 마지막 1년에 들어간다. 심지어 그 비용의 절반이 연명치료 마지막 한 달에 쓰인다. 2009년 500만 원이던 부담이 2019년 1500만 원으로 세배 뛰었다. 또 5년이 지났으니 2000만 원을 넘었을지도 모르겠다. ‘무조건 살려 달라’ ‘할 수 있는 건 다 해 달라’는 맹목적 감정보다는 이성적 판단이 필요하다. 2020년부터 연간 사망자가 30만 명을 넘으면서 출생자를 앞섰다. 10만 명이 무의미한 연명치료를 했다고 가정해도 러프하게 2조 원이 넘는다.”
―2022년 국내 최초로 국회에서 ‘조력존엄사법’이 발의됐다.
“엄밀히 말하면 산소호흡기 같은 연명의료를 거부하는 ‘소극적’ 방식과는 다르다. 극심한 고통을 겪는 말기환자에게 의사가 약물 등을 제공해 스스로 삶을 마무리할 수 있도록 돕는 ‘적극적’ 선택지를 제공하자는 것이다. 쉽게 말해 의사조력사망을 의미한다. 생명에 관한 문제라 섣불리 접근해서는 안 되지만 무조건 배제할 일은 아니다. 미국 오리건주가 1997년 세계 최초로 존엄사를 허용하는 주법을 만든 이후 2001년부터 네덜란드, 벨기에 등에서도 합법화됐다. 존엄사법이 세계적으로 빠르게 확산하는 이유를 살펴봐야 한다.”

―얼마 전 정부의 2차 호스피스, 연명의료종합계획을 평가하자면.
“건강할 때 작성하는 사전연명의료의향서와 달리 정부가 추진하는 건 엄밀히 말해 ‘연명의료계획서’다. 말기와 임종기 구분은 비전문인·비의료인이 판단하기 쉽지 않다. 지금은 임종기에만 연명치료를 중단·유보할 수 있다. 임종기는 회생가능성이 없고 급속도로 증상이 악화해 사망이 임박한 상태로 말기와 개념 구분이 쉽지 않다. 연명의료 중단 이행시기를 앞당겨 ‘벼락치기’ 존엄사를 막자는 건 바람직한 방향이다.”
―‘원정 존엄사’가 사회적 문제로 떠오르고 있다.
“오죽하면 죽는 것도 돈 있는 사람만 가능하냐는 말까지 나온다. 프랑스의 유명배우 알랭 드롱이 스위스에서 안락사를 선언했다. 2022년에는 프랑스의 영화거장 장 뤼크 고다르 감독도 안락사로 영면했다. 프랑스에서 안락사는 여전히 불법이다. 결국 프랑스 마크롱 대통령도 본격적인 안락사 허용에 대한 국민 의견 수렴에 나섰다. 올해 안에 국가 차원의 방침이 결정될 것이다. 미국은 존엄사를 허용하는 주가 10곳을 넘었고, 캐나다·호주도 1∼2개 주에서 국가 전체로 확대됐다. 자기 결정권이나 개인의 자유 의지를 중시하는 서양권 문화라지만 몇 년 사이에 폭발적으로 늘어나는 추세다.”
―무의미한 연명치료 중단은 시대적 흐름인가.
“생명에 관한 문제이자 낯선 개념이라 심도 있고 깊이 있게 다뤄져야 한다. 다만 이미 아름다운 죽음을 맞이하기 위한 존엄사(안락사)는 21세기 어젠다가 된 지 오래다. 우리 사회도 이런 도도한 흐름에서 벗어날 수 없다. 하늘이 준 생명은 그 자체로 소중하지만 지속적인 고통을 감수하면서 무의미하게 생명을 연장하는 건 본인이나 가족에게도 도움이 안 된다. 본인의 ‘자기 결정권’이 웰다잉 문제의 핵심이다.”
―법이 오히려 삶을 쉽게 포기하도록 부추기는 건 아닌가.
“일반적인 개념으로 접근하면 그럴 수 있다. 하지만 의료 차원에서 보면 다르다. 극심한 고통이 수반되고 회복 가능성이 없는데 굳이 무의미한 생명을 유지하는 게 옳은가 되묻고 싶다. 어찌 보면 의식이 꺼져가는 상황에서 준비된 죽음은 인생에서 가장 필요한 준비작업이자 삶의 소중한 일부분이다.”
김기동 논설위원
https://v.daum.net/v/20240501060528723
"심장 폭행당했다" 하루아침 스타 된 성동구 순찰견 '호두'
윤한슬 2024. 4. 30. 19:30
최근 반려견 순찰대로 선발
앙증맞은 체구로 순찰
덩치 큰 반려견 사이에서 눈길

최근 서울 성동구 '반려견 순찰대'로 뽑힌 포메라니안 '호두'. 정원오 성동구청장 SNS 캡처
서울 성동구의 '반려견 순찰대'로 활동하는 강아지 '호두'가 순찰대원 임무를 부여받자마자 스타덤에 올랐다. 작고 귀여운 체구에도 늠름하게 순찰을 도는 호두의 모습에 '랜선 견주'들이 미소를 감추지 못하고 있다.
30일 성동구청에 따르면 반려견 호두는 최근 마을 치안 활동을 하는 반려견 순찰대로 뽑혀 20일부터 본격적인 순찰활동을 시작했다. 호두는 세 살 난 암컷 포메라니안이다.
사회관계망서비스(SNS)에서는 체구가 작은 포메라니안이 반려견 순찰대로 지원했다는 소식이 일찌감치 화제가 됐다. 보통 진돗개나 레트리버 등 몸집이 큰 개들이 반려견 순찰대로 많이 활동하고 있어서 비교적 몸집이 작은 호두는 선발 당시부터 많은 주목을 받았다.

서울 성동구 반려견 순찰대원 호두의 순찰 모습. 정원오 성동구청장 SNS
호두를 향한 관심이 치솟자 정원오 성동구청장은 전날 자신의 SNS에 "저 이런 거 혼자만 보는 매정한 사람 아니다"라며 호두 사진을 두 장 공개했다. 또 연달아 "단독 입수한 호두의 용맹한 모습, 좀 더 전해드린다. 호두의 반려인이 전해준 귀한 사진과 영상이다"라며 호두가 순찰을 돌고 있는 영상과 사진을 공유했다.
영상 속 호두는 반려견 순찰대라고 적힌 형광색 순찰대원복을 입은 채 앙증맞은 모습으로 순찰을 돌고 있다.
정 구청장은 "올해도 성동구의 반려견 순찰대원들이 본격적인 활동을 시작했는데, 지난 주말엔 합동순찰에도 나섰다고 하니 그 활약이 벌써부터 기대된다"며 "길에서 반려견 순찰대원들을 마주하면, 반갑게 맞아달라"라고 응원을 독려했다.

최근 서울 성동구 반려견 순찰대원이 된 포메라니안 호두. 정원오 성동구청장 SNS 캡처
호두는 SNS를 중심으로 인기몰이를 하고 있다. 호두의 순찰 모습이 담긴 정 구청장의 게시물은 180만 회가량 조회될 정도로 화제가 됐다. SNS엔 "너무 귀여워서 범죄 예방되겠다", "이렇게 작은데 누가 누굴 지키냐. 차라리 내가 지켜 주겠다", "범죄 예방은커녕 심장 폭행당했다" 등 뜨거운 반응이 쏟아졌다.
반려견 순찰대는 전국 최초로 서울시 자치경찰위원회에서 2022년 도입한 것으로, 반려동물 산책과 치안 활동을 결합한 형태의 지역 치안 정책이다. 반려견과 반려인이 동네를 산책하며 망가져 고쳐야 할 시설물은 없는지, 도움이 필요한 사람은 없는지 살피고 신고하는 등 지역 지킴이 역할을 수행하고 있다.
호두 견주 엄호상 씨는 "산책하다가 반려견 순찰을 하고 있는 강아지를 보고 귀여워 보여 저와 호두도 해보고 싶다는 생각이 들었다"며 "평소에도 안전 관련 신고를 했던 데다 가족인 호두와 함께 하는 거라 큰 어려움은 없다"라고 말했다.
반려견 순찰대로 선발되려면 까다로운 심사를 통과해야 한다. 심사위원들은 △'기다려'와 '이리 와' 지시에 대한 반응 △줄을 느슨하게 당기지 않고 걸었을 때의 반응 △낯선 사람이 다가올 때 보호자 옆에서 침착하게 대응하는지 여부 △멀리서 다른 개를 봤을 때 보호자에게 집중하는지 여부 △다른 개가 지나갈 때 차분히 지나치는지 여부 등을 점검하고 각 상황에 맞는 점수를 부여한다.
윤한슬 기자 1seul@hankookilbo.com
https://youtu.be/iizuxd0-azg?si=y2tHOtaUSo5sgBX_
https://youtu.be/Kdl5fwDq0nQ?si=cVfiHXFnIgzLZqr9
https://youtu.be/SQNFwl4mujs?si=qE4U-F4BVKu5s1nX
https://youtu.be/cRHyvMOLZJM?si=VLXGl3qVP3IeoCyM
https://youtu.be/p_fLlTp9jg4?si=rwg6uES-S2cgZlRG
https://youtu.be/nx5-fgi4pPI?si=dpJT5XDqJSZ325R6
https://youtu.be/Db2ps3yQzLI?si=jqAwjDMDhTQCOyRU
https://youtu.be/cYFIPZnDfcE?si=bNiWFui_-4Uh07Oc
https://youtu.be/8fv_vTTy7c8?si=Wx5DGFYZ6pJrzc7s
https://youtu.be/e0_qprAofc8?si=ttkyaHUcb6Vz_rc_
https://youtu.be/vd72tYlWixY?si=0FGcuGsiR_Aqu6ec
https://www.youtube.com/live/yUKb4Sqq85s?si=K9qwNoPhhvdK8ArC
https://youtu.be/xaRAa9_mXfE?si=HXPsZWIz8_LZhv02
https://youtu.be/hvaov-wbfYw?si=L6MyxmrVFh-dHd9N
https://youtu.be/r64-CfnNbZ8?si=K_dtuxkteHUP1bMk
https://youtu.be/PsjBjPthxcA?si=Mqj_Zm9BlXVyFEjT
https://www.youtube.com/live/1P18ZVq17b4?si=Jz0YPLnUbaW7yaUd
https://youtu.be/PTvdMq77oPc?si=ZJZhV1Fkq4VeJt9t